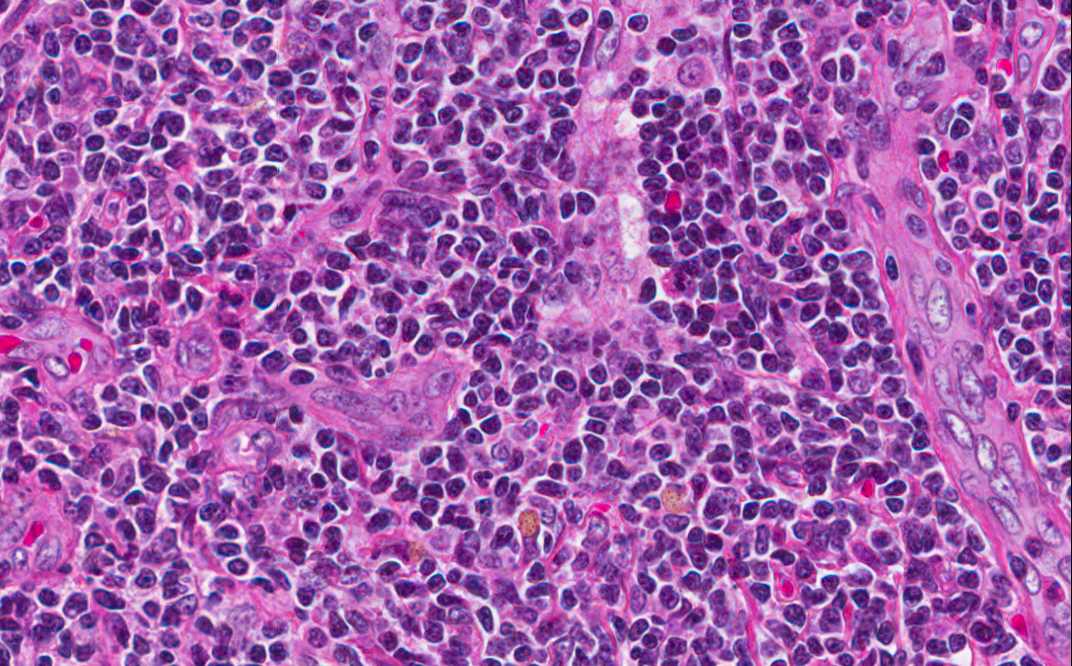

Изображения клеток Ашкенази Гюртля: подборка

Раздел: Мир вокруг нас